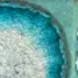

Produits similaires
Produits similaires

Décoration Murale Céleste - Soleil Lune Étoiles Fait Main, Cadeau Bohème en vente B2B
Prix revendeur
PVC : 113,77 $
Couleur
Meilleures ventes assorties
Livraison et politiques
- Date de livraison estimée : 17 avr.–14 mai
Retours gratuits et faciles. En savoir plus
Achetez des produits B2B uniques pour votre magasin sur Faire auprès de marques telles que Dock 6 Pottery et bien plus encore.
Description
Nos tentures murales célestes sont fabriquées à la main par notre équipe d'artisans à Minneapolis, dans le Minnesota. Chaque pièce est fabriquée à la main et est unique en son genre ; il n'y en a pas deux pareilles ! Mesure environ 24 pouces de long et 5 pouces de large. Chaque pièce est créée à la main et assemblée à l'aide de ficelle. Les mesures sont donc approximatives et peuvent légèrement différer d'une pièce à l'autre. Les variations font partie intégrante du processus de poterie artisanale, et des variations par rapport à l'image de l'échantillon sont à prévoir. Veuillez consulter les photos de l'annonce, le nuancier et nous contacter avant de commander pour toute question ou préoccupation concernant les variations. Nous sommes fiers de créer des pièces uniques et époustouflantes, et nous veillerons à ce que la pièce que vous recevrez soit absolument magnifique. tenture murale en forme d'étoiles, croissant de lune, phases de lune, guirlande de lune, cycle lunaire, décoration cadeau bohème, cadeaux pour femmes, astrologie, tapisserie murale, décoration murale, céramique en grès, géode art, tranche de géode, accent de maison tendance, demi-lune, art de sorcière, fabriqué à la main
Ce texte a été traduit automatiquement.
Détails
Pays de fabrication : États-Unis Saison : Automne Style : Bohème Thème : Céleste Poids : 453,59 g (1 lb) Dimensions : 61 x 12,7 cm (24 x 5 in) Matériaux du produit : Revalorisés Emballage : Recyclable et Recyclé Production : Approvisionnement éthique
Plus d'articles de cette marque
Plus d'articles de cette marque
Plus d'articles de cette marque
Plus d'articles de cette marque
Tout afficherÉvaluations et avis
Pertinence
Top Shop met à l'honneur les marques exceptionnelles qui ont obtenu une note de plus de 4,8 au cours des 12 derniers mois, traitent les commandes rapidement et sans erreur et proposent un catalogue à jour.
4,9
Note de la marque ()
5
5
178
178
4
4
6
6
3
3
2
2
2
2
1
1
1
1
0
0
5,0
Qualité des produits
5,0
Traitement
5,0
Communication
Le produit Décoration Murale Céleste - Soleil Lune Étoiles Fait Main, Cadeau Bohème n'a pas encore reçu d'avis.
Avis sur des produits similaires de la marque Dock 6 Pottery : Décorations murales
Absolument magnifique en personne ! Céramiques de premier ordre. Juste magnifique 💖
Absolument magnifique en personne ! Céramiques de premier ordre. Juste magnifique 💖
Apr 28, 2025 • Marnie • Sacramento, CA, États-Unis
Toutes les pièces en céramique étaient très bien faites et expédiées en toute sécurité, et j'en commanderai d'autres si nécessaire.
Toutes les pièces en céramique étaient très bien faites et expédiées en toute sécurité, et j'en commanderai d'autres si nécessaire.
Mar 18, 2024 • layne • Haleiwa, HI, États-Unis